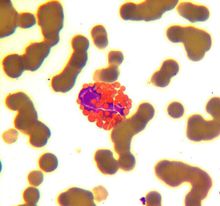
氯黴素

說明書
技術參數
| 英文名稱: | chloroamphenicol |
| CAS ,NO: | >,!--,56-75-7 |
| 分子量: | 323.13 |
| EC ,NO: | 200-287-4 |
| 分子式: | C11H12Cl2N2O5 |
 氯黴素
氯黴素英文名稱 : chloroamphenicol
英文別名:chloramphenicol; 2,2-dichloro-n-[2-hydroxy-1-(hydroxymethyl)-2-(4-nitrophenyl)ethyl]acetamide; d-(-)-threo-2,2-dichloro-n-[beta-hydroxy-alpha-(hydroxy-methyl)-p-nitrophenethyl]acetamide; chloromycetin; 2,2-dichloro-N-[(1R,2S)-1,3-dihydroxy-1-(4-nitrophenyl)propan-2-yl]acetamide; 2,2-dichloro-N-[(1S,2R)-1,3-dihydroxy-1-(4-nitrophenyl)propan-2-yl]acetamide; 2,2-dichloro-N-[(1R)-2-hydroxy-1-(hydroxymethyl)-2-(4-nitrophenyl)ethyl]acetamide
中文別名 : D-蘇式-(-)-N-[alpha-(羥基甲基)-beta-羥基-對硝基苯乙基]-2,2-二氯乙醯胺
CAS RN 56-75-7
EINECS號 : 200-287-4
分子式 : C11H12Cl2N2O5
分子量 :323.1294
風險術語: R45
安全術語 :S45;S53
熔點 :149-153°C
比鏇光度 :19.5° (c=6, EtOH)
水溶性 :2.5 g/L (25° C)
性狀:白色針狀或微帶黃綠色的針狀、長片狀結晶或結晶性粉末;味苦。在甲醇、乙醇、丙酮、丙二醇中易溶。在乾燥時穩定,在弱酸性和中性溶液中較安定,煮沸也不見分解,遇鹼類易失效。
用途 :用於治療由傷寒桿菌、痢疾桿菌、大腸桿菌、流感桿菌、布氏桿菌、肺炎球菌等引起的感染氯黴素(chloramphenicol,chloromycetin)是由委內瑞拉鏈黴菌產生的抗生素。
化學中文名稱:D-蘇式-(-)-N-[α-(羥基甲基)-β-羥基-對硝基苯乙基]-2,2-二氯乙醯胺
命名:(1R,2R)-N-[α-(羥基甲基)-β-羥基-對硝基苯乙基]-2,2-二氯乙醯胺
化學英文名稱:2,2-Dichloro-N-[2-hydroxy-1-(hydroxymethyl)-2-(4-nitrophenyl)ethyl]acetamide氯黴素的化學結構含有對硝基苯基、丙二醇與二氯乙醯胺三個部分,分子中還含有氯。其抗菌活性主要與丙二醇有關。
用法用量
稀釋後靜脈滴注。成人一日2~3g,分2次給予;小兒按體重一日25~50mg/kg,分3~4次給予;新生兒一日不超過25mg/kg,分4次給予。
主要用途
屬廣譜抑菌抗生素,是治療傷寒,副傷寒的首選藥,治療厭氧菌感染的特效藥物之一,其次用於敏感微生物所致的各種感染性疾病的治療。由於不良反應嚴重現用得越來越少。
生化作用
氯黴素類抗生素可作用於細菌核糖核蛋白體的50S亞基,而阻撓蛋白質的合成,屬抑菌性廣譜抗生素。
 氯黴素
氯黴素細菌細胞的70S核糖體是合成蛋白質的主要細胞成分,它包括50S和30S兩個亞基。氯黴素通過可逆地與
50S亞基結合,阻斷轉肽醯酶的作用,干擾帶有胺基酸的胺基醯-tRNA終端與50S亞基結合,從而使新肽鏈的形成受阻,抑制蛋白質合成。由於氯黴素還可與人體線粒體的70S結合,因而也可抑制人體線粒體的蛋白合成,對人體產生毒性。因為氯黴素對70S核糖體的結合是可逆的,故被認為是抑菌性抗生素,但在高藥物濃度時對某些細菌亦可產生殺菌作用,對流感桿菌甚至在較低濃度時即可產生殺菌作用。
氯黴素對革蘭陽性、陰性細菌均有抑制作用,且對後者的作用較強。其中對傷寒桿菌、流感桿菌、副流感桿菌和百日咳桿菌的作用比其他抗生素強,對立克次體感染如斑疹傷寒也有效,但對革蘭陽性球菌的作用不及青黴素和四環素。抗菌作用機制是與核蛋白體50S亞基結合,抑制肽醯基轉移酶,從而抑制蛋白質合成。
各種細菌都能對氯黴素發生耐藥性,其中以大腸桿菌、痢疾桿菌、變形桿菌等較為多見,傷寒桿菌及葡萄球菌較少見。細菌對氯黴素產生耐藥性比較慢,可能是通過基因的逐步突變而產生的,但可自動消失。細菌也可以通過R因子的轉移而獲得耐藥性,獲得R因子的細菌能產生氯黴素乙醯轉移酶(acetyltransferase)使氯黴素滅活。
作用機制
 氯黴素
氯黴素氯黴素自腸道上部吸收,一次口服1.0g後2小時左右血中藥物濃度可達到峰值(約10~13mg/L)。血漿
t1/2平均為2.5小時,6~8小時後仍然維持有效血藥濃度。氯黴素廣泛分布於各組織和體液中,腦脊液中的濃度較其他抗生素為高。氯黴素的溶解和吸收均與製劑的顆粒大小及晶型有關。肌內注射吸收較慢,血濃度較低,僅為口服同劑量的50%~70%,但維持時間較長。注射用氯黴素為琥珀酸鈉鹽,水中溶解度大,在組織內水解產生氯黴素。
氯黴素在體內代謝大部分是與葡萄糖醛酸相結合,其原形藥及代謝物迅速經尿排出,口服量5%~15%的有效原形藥經腎小球過濾而排入尿中,並能達到有效抗菌濃度,可用於治療泌尿系統感染。腎功能不良者使用時應減量。
藥理性能
 氯黴素
氯黴素為廣譜抑菌劑。通過脂溶性可彌散進入細菌細胞內,主要作用於細菌70s核糖體的50s亞基,抑制轉肽
酶,使肽鏈的增長受阻,抑制了肽鏈的形成,從而阻止蛋白質的合成。高濃度時或對本品高度敏感的細菌也呈殺菌作用。
氯黴素一般對革蘭氏陰性菌作用較革蘭氏陽性菌強。敏感菌有腸桿菌科細菌(如大腸桿菌、產氣腸桿菌、克雷伯氏菌、沙門氏菌等)及炭疽桿菌、肺炎球菌、鏈球菌、李斯特氏菌、葡萄球菌等。衣原體、鉤端螺鏇體、立克次體也對本品敏感。本品對厭氧菌如破傷風梭菌、產氣莢膜桿菌、放線菌及乳酸桿菌、梭桿菌等也有相當作用。但對綠膿桿菌、結核桿菌、病毒、真菌等均無效。
細菌對氯黴素有發展緩慢的耐藥性,主要產生乙醯轉移酶。通過質粒傳遞而獲得。某些細菌的一些菌株(綠膿桿菌、變形桿菌、克雷伯菌等)也因改變了細菌胞壁通透性,使氯黴素不能進入菌體而耐藥。
臨床套用
 氯黴素
氯黴素氯黴素曾廣泛用於治療各種敏感菌感染,後因對造血系統有嚴重不良反應,故對其臨床套用現已做出嚴
格控制。可用於有特效作用的傷寒、副傷寒和立克次體病等及敏感菌所致的嚴重感染。氯黴素在腦脊液中濃度較高,也常用於治療其他藥物療效較差的腦膜炎患者。必要時可用靜脈滴注給藥。由於氯黴素可引起嚴重的毒副作用,故臨床僅用於敏感傷寒菌株引起的傷寒感染、流感桿菌感染、重症脆弱擬桿菌感染、腦膿腫、肺炎鏈球菌或腦膜炎球菌性腦膜炎同時對青黴素過敏的患者。套用時療程避免過長,既往有藥物引起血液學異常病史的病人應禁用。所有套用氯黴素治療的病人在開始治療時必須檢查白細胞、網織細胞與血小板,並每3~4天複查一次,若出現白細胞減少應立即停藥。嬰幼兒套用氯黴素應十分謹慎,除非無其他藥物替代而必須使用時方考慮,有條件時可進行血藥濃度監測。
甲碸黴素與氯黴素是同一類抗生素,僅是氯黴素苯環上的硝基為一甲碸基所取代,其抗菌譜與氯黴素相似。甲碸黴素主要從腎臟排泄,尿中活性濃度較氯黴素高,故腎功能不良時需減小劑量。雖然也有血液系統毒性,但均為可逆性變化,不出現再生障礙性貧血。有的國家認為其療效優於氯黴素,但中國認為療效並不優於氯黴素。
不良反應
 傷寒沙門菌
傷寒沙門菌主要不良反應是抑制骨髓造血機能。症狀有二:一為可逆的各類血細胞減少,其中粒細胞首先下降,這
一反應與劑量和療程有關。一旦發現,應及時停藥,可以恢復;二是不可逆的再生障礙性貧血,雖然少見,但死亡率高。此反應屬於變態反應與劑量療程無直接關係。可能與氯黴素抑制骨髓造血細胞內線粒體中的與細菌相同的70S核蛋白體有關。為了防止造血系統的毒性反應,應避免濫用,套用時應勤查血象,氯黴素也可產生胃腸道反應和二重感染。此外,少數患者可出現皮疹及血管神經性水腫等過敏反應,但都比較輕微。新生兒與早產兒劑量過大可發生循環衰竭(灰嬰綜合徵),這是由於他們的肝發育不全,排泄能力差,使氯黴素的代謝、解毒過程受限制,導致藥物在體內蓄積。因此,早產兒及出生兩周以下新生兒應避免使用。
[注意事項]
包括有氯黴素、甲碸黴素及無味氯黴素等。氯黴素為廣譜抗生素,由於其對血液系統的毒性較大,故已較少用。外用其滴眼劑防治眼部感染。注意:主要不良反應有粒細胞及血小板減少、再生障礙性貧血等。久用可致視神經炎 、共濟失調及二重感染等。有時有消化道反應。新生兒可致灰嬰綜合症,故禁用。精神病人可致嚴重反應,故禁用。肌注易致嚴重反應。甲碸黴素抗菌譜與氯黴素相似,且不會出現再生障礙性貧血。但是腎功能不良時需減小劑量。兒童可服用無味氯黴素。
藥物相互作用
氯黴素
氯黴素配伍注意:本品注射劑,遇強鹼性及強酸性溶液,易被破壞失效。
(1)大環內酯類和林可黴素類抗生素的抗菌作用機理與氯黴素相似,可替代或阻止氯黴素與細菌核糖體的50s亞基相結合,故兩者同用可發生拮抗而不宜聯合套用。
(2)氯黴素是抑制細菌蛋白質合成的抑菌劑,對青黴素類殺菌劑的殺菌效果有干擾作用。應避免兩類藥物同用。
(3)氯黴素能拮抗維生素B6,使機體對B6的需要量增加,亦能拮抗維生素B12的造血作用。
(4)氯黴素對肝臟微粒體的藥物代謝酶有抑制作用,能影響其他藥物的藥效,如顯著延長動物的戊巴比妥鈉麻醉時間等。
(5)本品與某些抑制骨髓的藥物如秋水仙鹼、保泰松和青黴胺等同用,可增加毒性。
套用注意
1.開始治療前應檢查血象(白細胞、分類及網織細胞計數),隨後每48小時再查一次,治療結束還要定期檢查血象,一旦出現異常,應立即停藥。
2.氯黴素治療時,對用口服降血糖藥的糖尿病患者或服抗凝血藥者,尤其是老年人,應分別檢測血糖及凝血酶原時間,以防藥效及毒性增強。
3.對肝腎功能不良,G-6PDH缺陷者、嬰兒、孕婦、乳婦應慎用。
4.用藥時間不宜過長,一般不超過二個月,能達到防止感染復發即可,避免重複療程。
製劑與用法
鹽酸四環素(tetracyclinehydrochloride)口服:0.25~0.5g/次,3~4次/日。
鹽酸土黴素(oxytetracyclinehydrochloride)口服一次0.5g,3~4次/日。8歲以下小兒30~40mg/kg/日,分3~4次服用。
多西環素(doxycycline)成人首劑0.2g,以後0.1~0.2g/次,每日1次。兒童首劑4mg/kg,以後每日2~4mg/kg,每日1次。
米諾環素(minocycline)首劑0.2g,以後0.1g,每12小時1次。
氯黴素(chloramphenicol,chloromycetin)口服1.5-3g/日,每日4次,氯黴素肌注、靜注或靜滴0.5或1g,每12小時1次。
琥珀氯黴素(chlamphenicolsodiumsuccinate)注射劑:0.69(相當氯黴素0.5g),成人1~2g/日,分2~4次肌注或靜滴,兒童每日25~50mg/kg,分二次靜滴。
【化學合成】
氯黴素化學名為D-蘇式-(-)-N-[α-(羥基甲基)-β-羥基-對硝基苯乙基]-2,2-二氯乙醯胺,合成以對硝基苯乙酮為原料,溴化生成對硝基-α-溴代苯乙酮,與環六亞甲基四胺成鹽後,以鹽酸水解得對硝基-α-氨基苯乙酮鹽酸鹽,用醋酐乙醯化,再與甲醛縮合,羥甲基化得對硝基-α-乙醯氨基-β-羥基苯丙酮,以異丙醇鋁還原得(±)蘇阿糖型-1-對硝基苯基-2-乙醯氨基丙二醇,鹽酸水解脫去乙醯基,以鹼中和得(±)蘇阿糖型-1-對硝基苯基-2-氨基丙二醇(氨基物),用誘導結晶法進行拆分,得D(-)-蘇阿糖型氨基物,最後進行二氯乙醯化即得。
中國藥典
 氯黴素
氯黴素Lümeisu
Chloramphenicol
書頁號:2005年版二部-776
[修訂]
【檢查】 有關物質精密稱定本品適量,按氯黴素每10mg加甲醇1ml溶解後,用流動相定量稀釋製成每1ml中含0.5mg的溶液,搖勻,作為供試品溶液;另取氯黴素二醇物對照品與對硝基苯甲醛對照品適量,加甲醇適量溶解,用流動相定量稀釋成每1ml中含氯黴素二醇物5μg與對硝基苯甲醛5μg的混合溶液,作為雜質對照品溶液。照含量測定項下的色譜條件與系統適用性試驗,取雜質對照品溶液10μl注入液相色譜儀,調節檢測靈敏度,使氯黴素二醇物峰的峰高為滿量程的20%~25%;精密量取供試品溶液與雜質對照品溶液各10μl,分別注入液相色譜儀,記錄色譜圖。按外標法以峰面積計算,含氯黴素二醇物不得過1.0%,含對硝基苯甲醛不得過0.5%。
【含量測定】 照高效液相色譜法(附錄V D)測定。
色譜條件與系統適用性試驗 用十八烷基矽烷鍵合矽膠為填充劑;以水(含0.1 mol/L庚烷磺酸鈉溶液,0.05 mol/L磷酸二氫鉀與0.5%三乙胺,混勻,用磷酸調節pH至2.5)-甲醇(68:32)為流動相;流速為1.0ml/min;檢測波長為277nm;取氯黴素對照品、氯黴素二醇物與對硝基苯甲醛對照品各適量,加甲醇適量使溶解,用流動相稀釋製成每1ml中各含50μg的溶液,取10μl注入液相色譜儀,記錄色譜圖。理論板數按氯黴素峰計算不低於2500,相鄰峰的分離度應符合規定。
測定法 精密稱取本品適量,用甲醇溶解並用流動相定量稀釋製成每1ml中約含0.1mg的溶液,搖勻,精密量取10μl注入液相色譜儀,紀錄色譜圖;另精密稱取氯黴素對照品適量,同法測定。按外標法以峰面積計算供試品中C11H12CL2N2O5的含量。
[增訂]
【檢查】 殘留溶劑取本品約0.5g,置10ml量瓶中,加二甲亞碸溶解並稀釋至刻度,搖勻,作為供試品貯備液;精密量取供試品貯備液2ml,加二甲亞碸1ml,搖勻,作為供試品溶液;另精密取氯苯36mg、乙醇500mg,置100ml量瓶中,加二甲亞碸溶解並稀釋至刻度,搖勻,作為對照品貯備液;精密量取對照品貯備液1 ml,精密加供試品貯備液2ml,搖勻,作為對照溶液。照殘留溶劑測定法(附錄Ⅷ P第二法)測定,按外標法計算,含氯苯、乙醇應符合規定。若檢出其他溶劑,均應符合附錄“殘留溶劑測定法”中的限度規定。
功用作用
 氯黴素
氯黴素主要抗菌譜包括肺炎鏈球菌、化膿性鏈球菌、綠色鏈球菌、淋球菌、腦膜炎球菌、流感嗜血桿菌、李司忒菌、布氏桿菌、敗血出血性巴斯德桿菌、白喉桿菌、支原體、衣原體、立克次體、螺鏇體和一些厭氧菌。其中肺炎鏈球菌、流感嗜血桿菌、腦膜炎球菌較易發生耐藥。
金黃色葡萄球菌部分敏感。腸桿菌科的一些菌,如沙門菌(包括傷寒桿菌)、大腸桿菌、肺炎克雷白桿菌、奇異變形桿菌等大部菌株對本品敏感,但耐藥菌株已日見增多。沙雷桿菌、普魯威登菌、吲哚陽性變形桿菌、綠膿桿菌的多數菌株對本品耐藥。
口服吸收良好(75%~90%)。口服15mg/kg後2~3小時血藥達峰,為10~20μg/ml。靜脈滴注同量藥物的血藥峰濃度略高於上值。Vd為0.92L/kg,蛋白結合率約為50%,t1/2約為3小時。
 氯黴素
氯黴素新生兒的t1/2顯著高於成人,2周齡以下者t1/2約為24小時,2~4周齡者約為12小時。本品在體內分布良好,可進入胸水、腹水、滑膜液和玻璃體內,腦組織中藥物濃度可高於血清濃度幾倍,但腦脊液藥物濃度只為血清濃度的1/2。可透過胎盤,並進入乳汁。在膽汁中含量較低。
正常肝功能者,有90%藥物在肝內與葡萄糖醛酸結合失活,2%藥物脫乙醯基和脫氯,另有8%在尿中原形排泄。
主要用於傷寒、副傷寒和其他沙門菌、脆弱擬桿菌感染。與氨苄西林合用於流感嗜血桿菌性腦膜炎。由腦膜炎球菌或肺炎鏈球菌引起的腦膜炎,在病人不宜用青黴素時,也可用本品。外用治療沙眼或化膿菌感染。
藥代動力學
 氯黴素
氯黴素本品靜脈給藥後廣泛分布於全身組織和體液,在肝、腎組織中濃度較高,其餘依次為肺、脾、心肌、腸和腦組織。可透過血-腦脊液屏障進入腦脊液中,腦膜無炎症時,腦脊液藥物濃度為血藥濃度的21%~50%,腦膜有炎症時,可達血藥濃度的45%~89%,新生兒及嬰兒患者可達50%~99%。也可透過胎盤屏障進入胎兒循環,胎兒血藥濃度可達母體血藥濃度的30%~80%。還可透過血眼屏障進入房水、玻璃體液,並可達治療濃度。尚可分泌至乳汁、唾液、腹水、胸水以及滑膜液中。
表觀分布容積(Vd)為0.6~1L/kg。蛋白結合率約為50%~60%。血消除半衰期(t1/2b)成人為1.5~3.5小時,腎功能損害者為3~4小時,嚴重肝功能損害者血消除半衰期(t1/2b)延長(4.6~11.6小時),出生2周內新生兒血消除半衰期(t1/2b)為24小時,2~4周者為12小時,大於1月的嬰幼兒為4小時。在肝內游離藥物的90%與葡萄糖醛酸結合為無活性的氯黴素單葡萄糖醛酸酯。在24小時內5%~10%以原形由腎小球濾過排泄,80%以無活性的代謝產物由腎小管分泌排泄。透析對本品的清除無明顯影響。
適應症
 氯黴素
氯黴素1.傷寒和其他沙門菌屬感染:為敏感菌株所致傷寒、副傷寒的選用藥物,由沙門菌屬感染的胃腸炎一般不宜套用本品,如病情嚴重,有合併敗血症可能時仍可選用。
2.耐氨苄西林的B型流感嗜血桿菌腦膜炎或對青黴素過敏患者的肺炎鏈球菌、腦膜炎奈瑟菌腦膜炎、敏感的革蘭陰性桿菌腦膜炎,本品可作為選用藥物之一。
3.腦膿腫,尤其耳源性,常為需氧菌和厭氧菌混合感染。
4.嚴重厭氧菌感染,如脆弱擬桿菌所致感染,尤其適用於病變累及中樞神經系統者,可與氨基糖苷類抗生素聯合套用治療腹腔感染和盆腔感染,以控制同時存在的需氧和厭氧菌感染。
5.無其他低毒性抗菌藥可替代時治療敏感細菌所致的各種嚴重感染,如由流感嗜血桿菌、沙門菌屬及其他革蘭陰性桿菌所致敗血症及肺部感染等,常與氨基糖苷類聯合。
6.立克次體感染,可用於Q熱、落磯山斑點熱、地方性斑疹傷寒等的治療。
注意事項
1.由於可能發生不可逆性骨髓抑制,本品應避免重複療程使用。
 對眼部疾病有療效的氯黴素滴眼液
對眼部疾病有療效的氯黴素滴眼液2.肝、腎功能損害患者宜避免使用本品,如必須使用時須減量套用,
有條件時進行血藥濃度監測,使其峰濃度在25mg/L以下,谷濃度在5mg/L以下。如血藥濃度超過此範圍,可增加引起骨髓抑制的危險。
3.在治療過程中應定期檢查周圍血象,長程治療者尚須查網織細胞計數,必要時作骨髓檢查,以便及時發現與劑量有關的可逆性骨髓抑制,但全血象檢查不能預測通常在治療完成後發生的再生障礙性貧血。
4.對診斷的干擾:採用硫酸銅法測定尿糖時,套用氯黴素患者可產生假陽性反應。
孕婦及哺乳期婦女用藥
由於氯黴素可透過胎盤屏障,對早產兒和足月產新生兒均可能引起毒性反應,發生“灰嬰綜合徵”,因此在妊娠期,尤其是妊娠末期或分娩期不宜套用本品。
本品自乳汁分泌,有引致哺乳嬰兒發生不良反應的可能,包括嚴重的骨髓抑制反應,因此本品不宜用於哺乳期婦女,必須套用時應暫停哺乳。
兒童用藥
新生兒由於肝臟酶系統未發育成熟,腎臟排泄功能又差,藥物自腎排泄較成人緩慢,故氯黴素套用於新生兒易導致血藥濃度過高而發生毒性反應(灰嬰綜合徵),故新生兒不宜套用本品,有指征必須套用本品時,如有條件應在監測血藥濃度條件下使用。
老年患者用藥
老年患者組織器官大多退化,功能減退,自身免疫功能亦降低,氯黴素可致嚴重不良反應,故老年患者應慎用。
